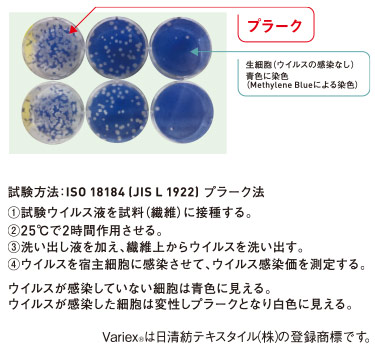

抗ウイルスパンツ[男女兼用](01-WH13186)
安心・安全の3つのSEKマーク
抗ウイルス加工でウイルス数を99.9%減少できる! 制菌加工、抗菌防臭加工でさらに高機能!
ウイルスと細菌の違い
| ウィルス | 細菌 | ||||||||||||
|---|---|---|---|---|---|---|---|---|---|---|---|---|---|
| 大きさ | ![]() |
||||||||||||
| 大きさが約20~300nmの有害粒子 | 大きさが約1μmの微生物 | ||||||||||||
| 増殖方法 | ウイルス単独では生存できない。自分自身で増殖する能力が無く、他の生物を宿主にして自己を複製することで増殖する。 | 自己複製能力を持った微生物。糖などの栄養と水があり、適切な環境のもとでは、生きた細胞がなくても自分自身で増殖できる。 | |||||||||||
ウイルス減少の比較
| 抗ウイルス性のウイルス減少比較 | 抗ウイルス加工のウイルス減少比較 | ||||||||
|---|---|---|---|---|---|---|---|---|---|
![]() |
![]() |
Variexは、SEKマークを取得し、各種安全性試験をクリアした素材です。
| 急性経口毒性 | LD50、ラット>2000mg/kg(製剤推定値) |
|---|---|
| 変異原性 | Ames Test、陰性 |
| 皮膚刺激性 | 異常無 |
| 皮膚感作性 | 異常無 |
| 皮膚貼付試験 | 陰性 |
抗ウイルス加工のご注意
●抗ウイルス加工は、病気の治癒や予防を目的とするものではありません。●抗ウイルス性試験は、ウイルス株:ATCC VR-1679(エンベロープ有)を25℃で2時間放置して実施しています。
●抗ウイルス加工は、ウイルスの働きを抑制するものではありません。
Item detail商品詳細
「抗ウイルス」「制菌加工」「抗菌防臭加工」3つの強力なウイルス対策
抗ウイルス加工「バリエックス」を施したポプリン素材。さらに「制菌加工」「抗菌防臭加工」をプラスした高機能素材です。


ウエスト腰ひも仕様
ウエストは総ゴム+内側にひもをセット。フロントファスナー
パンツのフロントにファスナー付。

ヒップポケット
後ろ右腰にポケット付きで便利度がグッとアップ。股ガゼット仕様
股ガゼット仕様で動きやすさがアップ

コーディネートCoordinate
コーディネートアイテム
-
01-WH13185
抗ウイルススクラブ[男女兼用](01-WH13185)
3,927円(税込)
-
01-WH13150
抗ウイルス予防衣[男女兼用](01-WH13150)
4,851円(税込)
商品説明Description
繊維上の特定のウイルスの数を99.9%以上減少します。抗ウイルス性と安全性を兼ね備えた抗ウイルス素材Variexを使用しています。「抗ウイルス」「制菌」「抗菌防臭」の3つのSEKマークを取得した高機能素材です。ウエストが総ゴムなので着脱が楽にできます。
- 商品番号
- 01-WH13186
- 素材
- バリエックスポプリン(ポリエステル65%、綿35%)
- 仕様
- ウエスト総ゴム・腰ひも、フロントファスナー、ヒップポケット、股ガゼット
- 機能
- 抗ウイルス加工、制菌加工、抗菌防臭加工
サイズ詳細
| サイズ | SS | S | M | L | LL | 3L | 4L |
|---|---|---|---|---|---|---|---|
| ウエスト | 58-66 | 64-72 | 70-78 | 76-84 | 82-90 | 88-96 | 94-102 |
| ヒップ | 97 | 101 | 105 | 109 | 115 | 121 | 127 |
| 股下(フリー) | 85 | 85 | 90 | 90 | 90 | 90 | 90 |
シリーズ商品Series item
商品を選択する
この商品を購入された方のレビュー
総合評価
0